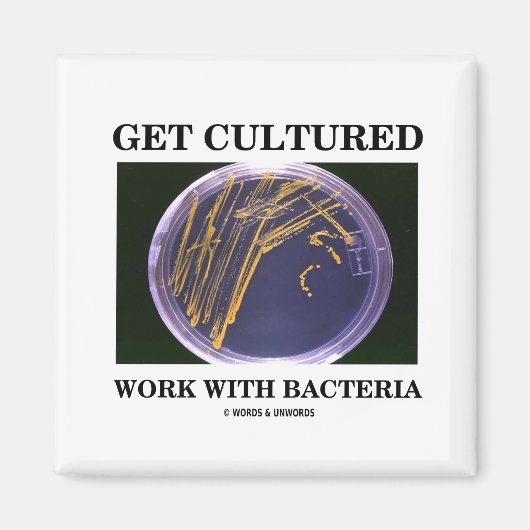
バクテリアで培養物を得る(寒天プレート) マグネット (正面)

マグネットについて
販売:
このデザインについて
バクテリアで培養物を得る(寒天プレート) マグネット
寒天プレートに細菌を載せたこれらのギフトと、科学的な利己主義ことわざ「細菌で培養作業を得る」と共に、あなたの苦情的な細菌感を披露する。細菌文化を含むこの二重エンテンダーことわざを理解するために人類学者や生物学者である必要はない!
自動翻訳
カスタマーレビュー
5つ星評価のうち星4.7全レビュー数 9
レビュー:9
類似商品のレビュー
5つ星評価のうち星5
アルフ2021年8月6日 • 認証済みのご注文
マグネット, スタイル: スクエア, サイズ: 5.08cm
Zazzleレビュープログラム
しっかりした作りで、磁石も強力なので、何かを留めるのも割りとしっかり留めてくれる。
飾りとしても、かっこいい! とてもキレイでした。色合いも良かったです。
5つ星評価のうち星5
榊原 利幸2019年5月20日 • 認証済みのご注文
マグネット, スタイル: スクエア, サイズ: 5.08cm
Zazzleレビュープログラム
以前、このデザインのエコバックを作っていただきました。
今回は、「砂の植物相」とペアで、マグネットを作って戴きました。
双方とも、クレーのデザインと色が秀逸です。 クレーならではの色が、良く出ていて可愛く素敵です。
5つ星評価のうち星5
榊原 利幸2019年5月24日 • 認証済みのご注文
マグネット, スタイル: スクエア, サイズ: 5.08cm
Zazzleレビュープログラム
30年前のウィーン世紀末展で見、学生の頃ポスターを貼っていた。
くり抜くパーツのセンスが、一番良かった。 暗過ぎず、明る過ぎず、丁度良く、発色が素晴らしい。
タグ
その他の情報
商品 ID: 147565088595192425
出品日: 2011/3/30 6:58
レーティング: G
最近閲覧された商品